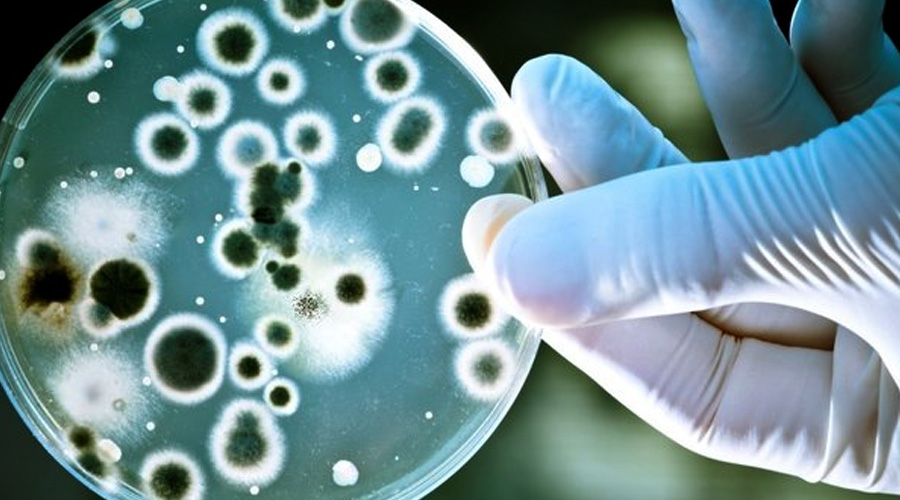

Cumhurbaşkanı Recep Tayyip Erdoğan, Kovid-19 salgını nedeniyle 65 yaş üstü vatandaşlar ile kronik hastalığı bulunan vatandaşların sokağa çıkmalarına kısıtlama getirildiğini duyurmuştu. Peki, Kronik hastalık nedir? Kronik hastalıklar neler? İşte ayrıntılar…
KRONİK HASTALIK NEDİR?
Kronik hastalık, müzmin, süreğen ve vücudun bir bölgesini etkileyen, uzun zaman devam eden, bazı durumlarda ömür boyu iyileşmeyen ve tedavi olanakları daha sınırlı olan hastalık çeşididir. Kalp yetmezliği, ritim problemleri, tansiyon gibi kalp sağlığını olumsuz etkileyen hastalıklar, kronik hastalıkların başında gelmektedir.
ÖZELLİKLERİ
Genellikle tam bir iyileşme sağlanamaz. Çoğunlukla orta yaşlarda görülür ve hayat boyu devam eder.
Kini zamanlarda iyileşme gösterse de zaman içinde nükseder.
Hastalığa neden olan durumlarla karşılaşma ile hastalığın ortaya çıkması arasında uzun süre geçebilir.
Hasta olan kişiye, düzenli tıbbi bakım gerekebilir.
Genellikle genetik nedenli olabilir veya risk faktörlerine maruz kalmaktan kaynaklanabilir.
Ekonomik olarak yükü ağırdır.
KRONİK HASTALIKLAR NELERDİR?
Koah: Kronik obstrüktif akciğer hastalığında (KOAH), hava akışı zayıflar. İlerleme eğilimindedir. En belirgin semptomları, öksürme, balgam üretimi ve nefes darlığıdır. KOAH hastalarının pek çoğunun kökeninde kronik bronşit hastalığı vardır.
Astım: Solunum yollarında devam eden enfeksiyon sonucu aşırı derecede duyarlı hale gelmesine ve bazı sebeplerle zaman zaman solunum yollarının daralmasına sebep olan bir solunum yolu rahatsızlığıdır.
Şeker hastalığı (diyabet): Halk arasında şeker hastalığı olarak bilinen diyabet, kanda bulunan şeker oranını düzenleyen insülin hormonunun eksik olduğu ve yeteri kadar salgılanmasına rağmen vücutta kullanılmadığı durumlarda ortaya çıkan bir hastalıktır.
Hipertansiyon: Yüksek tansiyon olarak bilinen hastalık, dünya genelinde insan ve toplum sağlığını tehdit etmekle birlikte, felç, böbrek yetmezliği, kalp krizi gibi ölümcül sonuçlara neden olan yaygın ve tehlikeli bir hastalıktır.
Kronik Böbrek Hastalığı: Kronik böbrek hastalığı, böbreklerin görevlerini yıllar boyu yapamamasıyla bilinen bir hastalıktır. Böbrek işlevinin kaybı kritik bir düzeye ulaştığında böbrek yetmezliği gelişir ve vücudun tüm organlarını etkileyen ciddi sorunlar ortaya çıkar.
